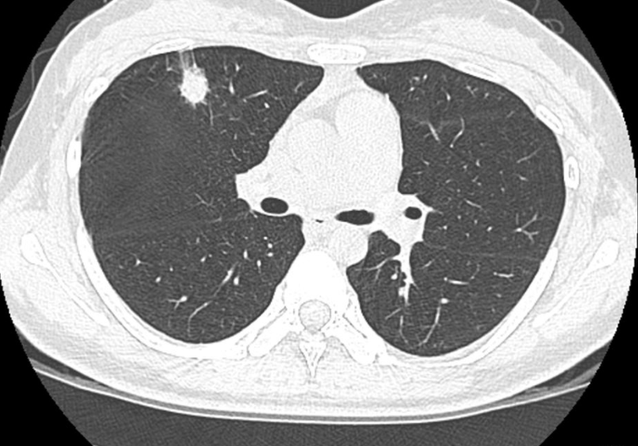
肺结节怎么治疗

现在患上肺病的人群是比较多的,而且还在呈现上涨的趋势,这就和自己的生活环境以及自己的饮食习惯有关。那么,肺结节怎么治疗呢?
来自河南的李大叔,现在已经51岁了,为了维持自己的生活,为了给自己的孩子更好的条件,他天天在工地上干活。
因为工地的粉尘比较多,导致李大叔经常感觉到喉咙不舒服,在4年前的时候发现自己咳嗽越来越严重,就去医院进行检测。
检测的结果让李大叔大吃一惊,原来自己的肺部竟然出现了小的病灶面积,大约在1.26×0.83左右。
经过综合的分析和诊断,医生断定为是肺结节,建议李大叔选择保守治疗的方式,可以给他省不少的钱,如果后期病灶发展再进行手术治疗。
李大叔听到自己身体有肺结节之后,非常的害怕,恐怕自己肺结节会发展成肺癌,所以回到村里之后就向大家咨询偏方。
有人说经常的喝黄芪水,可以有效的帮助消散肺当中的结节,所以李大叔就购买了很多,每天都坚持泡黄芪水喝,这个习惯坚持了4年。
一、51岁大叔坚持喝黄芪水,后来肺结节好了吗?
最近这段时间李大叔总是觉得自己胸闷气短,于是就去医院进行检查,没想到自己的婕婕非但没有变小,还在不断的增大,会出现这种情况,就和自己天天和黄芪有关。
虽然说黄芪有着补血益气清肺化痰的作用,但是作为中草药材,它并不适合天天服用,虽然黄芪可以帮助改善肺阴虚和肺气虚,但是它却对肺结节没有任何的效果。
医生也是告诫各位,当发现自己出现疾病的时候,要按照医生的医嘱及时的进行治疗,千万不要盲目的相信偏方。
二、养肺自己应该怎么做呢?
当发现自己肺部出现问题的时候,首先要做到的就是抓紧时间去医院进行检测和治疗,找到问题的根源,才可以更好的对症下药。
其次就是补充自己身体当中的营养来增强自身的抵抗力,除了改善自己的饮食之外,也需要适当的进行运动,这样可以增强自己的肺活量,增强自己肺部自我清洁的能力。
结语:在中医的字典当中,根本就没有养肺的这个说法,想要让自己的肺尽快的恢复健康,那么就需要让自己的肺部运行通畅,要保持良好的心情多喝水,都有利于肺部的自我修复。